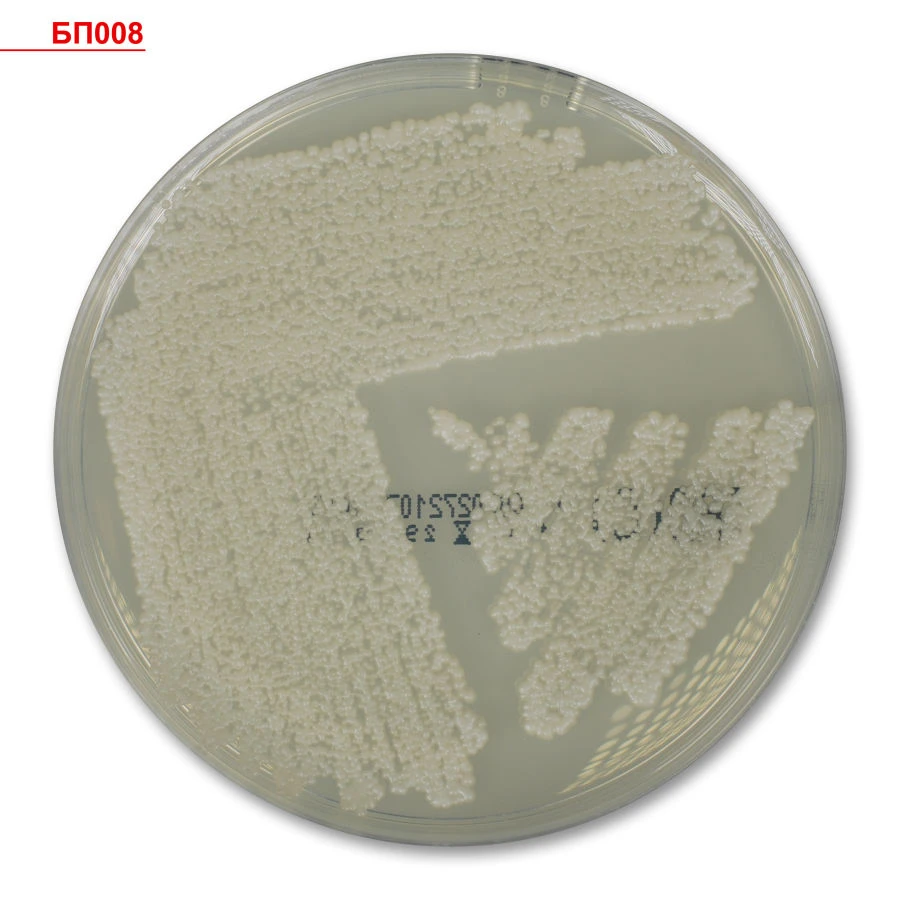
Selective Differential Diagnostic Nutrient Medium for Enterobacteria, Ready-to-Use, AGA

Селективная дифференциально-диагностическая плотная питательная среда для выделения энтеробактерий из исследуемого материала при проведении микробиологической диагностики in vitro.











Напишите что вам нужно и получите предложения от проверенных поставщиков